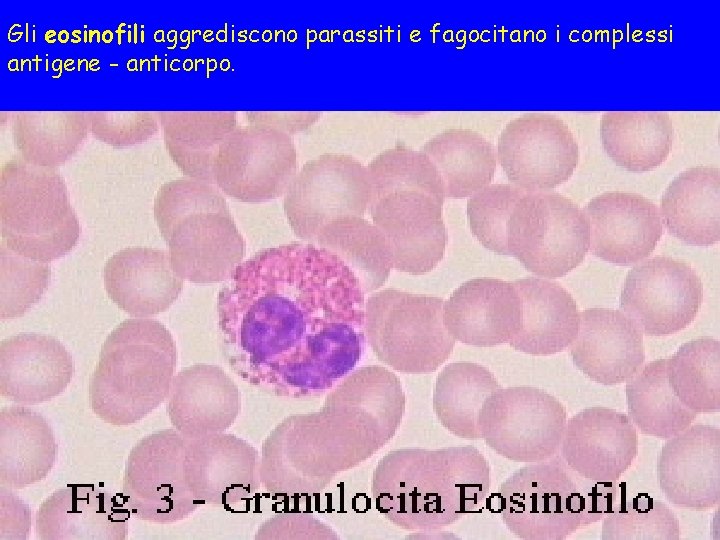
Gli eosinofili aggrediscono parassiti e fagocitano i complessi antigene - anticorpo.
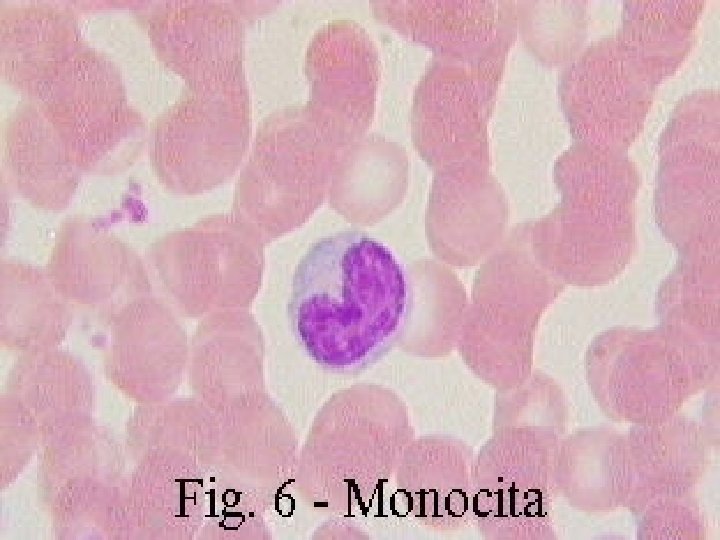

EMOCROMO EMOCROMO Contempla il conteggio del numero dei

- Slides: 90
EMOCROMO
EMOCROMO • Contempla il conteggio del numero dei globuli rossi (eritrociti), dei globuli bianchi (leucociti) e delle piastrine (trombociti), nonchè la determinazione quantitativa dell’emoglobina. • È detto anche esame emocromocitometrico che letteralmente significa "misurazione del colore del sangue e del numero delle sue cellule, cioè dei globuli“. • Con la formula leucocitaria si intende la percentuale di ciascun tipo di globulo bianco (granulociti neutrofili, eosinofili e basofili monociti, linfociti).
EMOCROMO La valutazione dell’emocromo era effettuata in passato per conta manuale all’interno di specifiche camere Attualmente l’emocromo viene effettuato utilizzando analizzatori ematologici automatizzati in grado di: 1. Determinare il volume cellulare 2. Determinare il numero cellulare 3. Determinare la conta differenziale dei leucociti 4. Determinare la concentrazione di emoglobina
EMOCROMO Eritrociti Analisi quantitative Conteggio Leucociti Piastrine Determinazione Emoglobina Ematocrito Morfologia eritrocitaria Analisi qualitative Morfologia piastrinica Morfologia leucocitaria Formula leucocitaria
EMOCROMO la determinazione dell’emocromo prevede anche: L’ANALISI DELLE CARATTERISTICHE FISICHE (FORMA, DIMENSIONI) DEI GLOBULI ROSSI E DELLE PIASTRINE. Queste sono indicate da speciali parametri come: MCV (misura delle dimensioni medie di un globulo rosso), MCH (indica la quantità media di emoglobina contenuta in un globulo rosso), MCHC (indica la concentrazione di emoglobina in un globulo rosso), RDW (indica le variazioni delle dimensioni dei globuli rossi) MPV (misura delle dimensioni medie di una piastrina).
Parametro Nome Valori di riferimento Cause di anormalità WBC White Blood Cells 4 -11 x 103/ l; 60% neutr. ; 30% linf. ; 5% mono; 4%eosino. ; 1% basof. infezioni; leucemie; processi infiamm. RBC Red Blood Cells 4. 5 -5. 5 x 106/ l 4 -5 x 106/ l anemie; leucemie HGB Hemoglobin 12 -15 g/dl anemie HCT Hematocrit 40 -50% 35 -45% MCV Mean Corpuscular Volume 80 -97 fl anemie; emoconcentrazione -talassemia; sideropenia; deficit B 12/folato MCH Mean Corpuscular Hemogl. 25 -34 pg RDW Red Cell Distribution 11 -16% Width Anemia sideropenica e megaloblastica PLT Platelets 150 -400 x 103/ l Aplasia, leucemie, CID MPV Mean Platelet Vol. 7 -10 f. L piastrinopatie Anemie ipocromiche
Emogramma normale L’emogramma normale è così rappresentato: - Eritrociti 4 -6 milioni/mmc - Leucociti 4 -10 mila/mmc - Piastrine sino a 350000/mmc - Emoglobina (Hbg) 12 - 16% (donne) 14 – 18 (uomini) - Linfociti 20 -35% - Monociti 3 -7% - Neutrofili 55 -65% - Eosinofili 0 -3% - Basofili 0 -2% ematocrito: 35 - 47 (donne); 40 -54 (uomini) volume globulare medio: da 80 a 100 micron cubi contenuto emoglobinico globulare medio, 24 -34 pcg concentrazione emoglobinica globulare media, da 32 a 36 su 100.
MODALITÀ DI ANALISI DEGLI ANALIZZATORI DI EMATOLOGIA • Il sangue intero viene fatto aspirare dallo strumento, che provvede automaticamente ad aliquotarlo con una valvola campionatrice in quantità distinte e a diluire ciascuna quantità per i conteggi e le analisi dei parametri ematologici • I conteggi e le analisi dei parametri ematologici sono effettuate in camere di lettura differenziate, applicando metodi/principi di analisi diversi
PRINCIPIO IMPEDENZIOMETRICO COULTER • Principio: Si basa sul fatto che le cellule sono cattivi conduttori di elettricità mentre il diluente è ottimo conduttore. • Funzionamento: 1)Diluiz. sangue in soluz. elettrolitica isotonica tamponata 2) Aspirazione del campione attraverso orifizi di diametro specifico 3) Mantenimento corrente costante tra due elettrodi (uno esterno ed uno interno rispetto alle camere di conta)
Metodo Coulter Ogni cellula che attraversa l’apertura del campo elettrico sostituisce un volume di diluente pari alle sue dimensioni. Ogni cellula provoca un cambiamento di corrente generando un impulso elettrico misurabile.
PRINCIPIO IMPEDENZIOMETRICO COULTER 75 f L 70 f L 65 f L 60 f L 55 f L 50 f L • Il passaggio della cellula attraverso il campo elettrico produce un impulso la cui ampiezza è direttamente proporzionale al suo volume. • Il numero di impulsi registrati consente il conteggio degli elementi cellulari • L’ analisi della ampiezza degli impulsi consente la differenziazione delle cellule che hanno prodotto gli impulsi
ISTOGRAMMI DIMENSIONALI Relative Number Histogram 23 24 25 26 27 28 29 30 31 32 33 34 35 36 37 38 Femtoliters • L’analisi volumetrica degli impulsi consente di costruire un istogramma dimensionale relativo a ciascuna popolazione cellulare (WBC, RBC, PLT) • Particolari tecnologie brevettate consentono di garantire la massima accuratezza di analisi
CONTEGGIO RBC E PIASTRINE • Il conteggio e il dimensionamento volumetrico di RBC e PLT viene eseguito nella stessa camera di lettura, con Principio Impedenziometrico • L’analisi dimensionale degli impulsi, con specifiche soglie volumetriche, consente di differenziare i RBC dalle PLT
ANALISI RBC MCV = average size of all the cells in the histogram. RDW = standard deviation x 100 Mean Size • Gli impulsi compresi tra 36 e 360 f. L sono classificati come RBC e vengono distribuiti su un istogramma dimensionale suddiviso in 256 canali volumetrici (1, 3 f. L /canale) • Dall’istogramma RBC viene eseguita la misurazione del MCV e del RDW MCV: Volume Medio dei Globuli Rossi, utile nella classificazione delle anemie (micro-, normo- macrocitiche ) RDW: Ampiezza della distribuzione dei Globuli Rossi, indice di Anisocitosi Eritrocitaria
ANALISI RBC: PARAMETRI CALCOLATI • MCH = Hb x 10 MCHC= Hb x 100 HCT = MCVx. RBC HCT 10 • MCH = Contenuto Medio di Emoglobina nei RBC. Particolarmente utile nella classificazione delle anemie (ipo- o normo- cromiche) in associazione al parametro MCHC • MCHC= Concentrazione cellulare Media di Emoglobina. Particolarmente utile nella classificazione delle anemie (ipo- o normo- cromiche) in associazione al parametro MCH • HCT= Ematocrito, esprime la % di volume occupata dai RBC nel volume totale di sangue intero.
ANALISI MORFOLOGIA RBC • • Anisocitosi +, +++ • L’analisi dei parametri eritrocitari (MCV, MCH, Microcitosi +, +++ MCHC, HCT, RDW) Macrocitosi +, +++ associata alla valutazione Ipocromia +, +++ dell’istogramma RBC Poikilocitosi +, +++ consente agli analizzatori Doppia Popolazione RBC di fornire utili flags di Micro RBC/Frammenti RBC anormalità morfologiche • Tali flag sono utili al Agglutinazione RBC laboratorio nella valutazione al microscopio degli strisci di sangue periferico
ANALISI PLT (PIASTRINE) #1 - Vengono raccolti i dati del triplice conteggio ed elaborato un primo istogramma con soglie da 2 fl a 20 fl. – Limite inferiore di 2 fl. Rimuove interferenze da noise elettronico – Limite superiore di 20 fl. Assicura che non vengano contati microciti e frammenti RBC
ANALISI PLT: PARAMETRI CALCOLATI • Dall’istogramma PLT vengono derivati ulteriori parametri quali: – PCT (ematocrito Piastrine) – MPV (Volume Medio PLT) – PDW (Ampiezza Distribuzione PLT, indice di Anisocitosi Piastrinica) • L’analisi dei parametri PLT (PCT, MPV, PDW) associata alla valutazione dell’istogramma PLT, RBC, WBC consente agli analizzatori di fornire utili flag di anormalità morfologiche, quali: – AGGREGATI PLT – PIASTRINE GIGANTI – TROMBOCITOPENIA, TROMBOCITOSI
ISTOGRAMMA PLT -NORMALE Conteggiate da 2 a 20 f. L Platelet Distribution Width S. D. (MPV) PDW = ------MPV x 100 Small Platelet MPV < 7 f. L Large Platelet MPV > 11 f. L Giant Platelet MPV > 20 f. L Valori di riferimento PLT: MPV: PCT: PDW: 140 -440 x 10^9/L 7. 4 -10. 4 f. L 0, 150 -0, 320 % 15. 5 -17. 5
DETERMINAZIONE HB Misura in Spettrofotometria dopo trasformazione dell’ Hb in Cianmetaemoglina, con reagente specifico, dedicato • Metodica: – Reagente Hb Modificato, ottimizzato per eliminare interferenze di Sulfoemoglobina – Misura fotometrica della Assorbanza campione. Filtro ad ampia banda, con valore centrale @ 525 nm. – Filtro Infrarosso per assorbimento calore – Misura del Bianco ad ogni campione
CONTEGGIO GLOBULI BIANCHI • Il campione diluito viene trattato con un particolare reagente che provoca la lisi completa dei globuli rossi • Tutti gli impulsi registrati con volume superiore a 35 fl. sono classificati e contati come Globuli Bianchi • Tutti gli impulsi registrati con volume inferiore a 35 fl. sono classificati e registrati come Piastrine o frammenti RBC lisati ed esclusi dal conteggio
Tecnologia VCS Analisi volumetrica Volume Analisi strutturale Complessità cellulare interna Conduttività Studio di dispersione della luce laser Granulazioni interne Superificie cellulare Scatter luce laser
CONTEGGIO GLOBULI BIANCHI In un conta globuli automatico è possibile determinare: Il Volume Cellulare per IMPEDENZIOMETRIA La Densità del Nucleo ed il Nucleo/Citoplasma per CONDUTTIVITA’ Rapporto La presenza di: Granulazioni Citoplasmatiche grazie allo SCATTER DI LUCE LASER
CONTEGGIO GLOBULI BIANCHI Tanto maggiore è la complessità cellulare tanto più elevata è la resistenza opposta dalla cellula al passaggio di corrente, e quindi tanto maggiore è la sua opacità. Tra gli elementi strutturali interni della cellula, il nucleo è quello con più bassa resistenza ed è quindi un ottimo conduttore di corrente. Cellule con elevato rapporto N/C (Linfociti) hanno una Opacità minore di cellule con rapporto N/C ridotto (Granulociti). La misura dello scatter di luce laser, combinata alle misure di Impedenza e Conduttività/Opacità, consente una classificazione completa delle popolazioni leucocitarie in base alle peculiari caratteristiche: volume cellulare, grandezza e densità del nucleo, rapporto N/C, granularità e superficie cellulare.
Tecnologia VCS – Formula Leucocitaria – Tutte le cinque popolazioni sono contate direttamente, senza calcoli o derivazioni matematiche – TRE diverse tecnologie di indagine applicate simultaneamente – Definizione delle popolazioni cellulari (cluster) con tecnologia Accu. Gate – Conservazione delle cellule allo stato NATIVO V - VOLUME C - CONDUTTIVITA’/OPACITA’ S - SCATTER DI LUCE LASER
SOFISTICATO SISTEMA DI SEPARAZIONE DELLE POPOLAZIONI CELLULARI, MEDIANTE ACCUGATE LINFOCITI NEUTROFILI BASOFILI MONOCITI EOSINOFILI
Anomalie Quantitative dei Leucociti Possibile definirle molto bene in funzione della estrema precisione nel conteggio TOTALE E DIFFERENZIALE dei Leucociti e diagnosticabili in funzione dei Valori Assoluti delle cellule • Neutropenie • Linfocitopenie • • • Neutrofilie Eosinofilie Basofilie Linfocitosi Monocitosi
ANTICOAGULANTI • Un anticoagulante è un composto capace di rallentare o interrompere il processo di coagulazione del sangue. • Gli anticoagulanti utilizzati in patologia clinica sono: • EDTA • Sodio Citrato • Fluoruro di sodio • ossalati
EDTA • La concentrazione del sale di- o tripotassico raccomandata è di 1, 5 ± 0, 25 mg/m. L di sangue. • Un eccesso di EDTA altera sia gli eritrociti che i leucociti provocando concentrazione e alterazioni degenerative. • Una quantità di EDTA superiore a 2 mg per m. L di sangue può portare ad una significativa diminuzione dell’ematocrito e ad un aumento dell’MCHC. • Anche le piastrine risentono dell’eccesso di EDTA (rigonfiamento e disintegrazione, aumento artificiale del numero delle piastrine perché i frammenti sono così grossi da essere contati come piastrine morfologicamente normali).
GLI ERITROCITI (RBC) SONO LE CELLULE PIÙ NUMEROSE DEL SANGUE VALORI NORMALI NELL’UOMO 4. 5 - 6 milioni/mmc NELLA DONNA 4 - 5. 5 milioni/mmc
Gli eritrociti maturi sono cellule prive di nucleo e di organuli cellulari, con un metabolismo energetico dipendente esclusivamente dall’ATP prodotto glicoliticamente. Sostanzialmente, la loro attività consiste nel trasporto dell’ossigeno e dell’anidride carbonica, mediante il legame a una proteina caratteristica: l’emoglobina
Una riduzione del numero dei globuli rossi può essere registrata in pazienti affetti da: anemie emorragie Un aumento del numero degli eritrociti alti può essere causato dall'altitudine o da un'intensa attività fisica, ed è stato riscontrato in pazienti che soffrono di: insufficienza respiratoria policitemia talassemia
ERITROCITI (RBC) Del diametro medio di 8 micron (8 millesimi di millimetro) a forma di disco Valori normali 4. 800. 000 - 5. 600. 000 /mmc (millimetro cubo) per l’uomo e 4. 600. 000 - 5. 200. 000 /mmc per la donna. All’esame è possibile calcolare anche altri parametri dei quali riportiamo anche i valori ritenuti normali: -MCD (Mean Corpuscolar Diameter = diametro medio di ciascun eritrocita) 7 -8 micron - MCV(Mean Corpuscolar Volume = volume medio dei globuli rossi) HMT/n° globuli rossi in milioni 80 -94 femtolitri
EMOGLOBINA (HGB) E’ LA PROTEINA CHE TRASPORTA L’OSSIGENO ED E’ PRESENTE NEI GLOBULI ROSSI. VALORI NORMALI DONNA 12 - 16 (g/dl) UOMO 14 - 18.
EMOGLOBINA (Hb) Sono considerati valori normali quelli compresi fra 14 -18 g/100 ml per gli uomini e 12 -16 g/100 ml per le donne Si misura l’assorbanza a 540 nm dell’emolisato Valori superiori a quelli considerati normali possono essere causati da diarrea, da disidratazione, da enfisema, da policitemia, da poliglobulia, da shock, da ustioni, da trasfusioni ripetute Valori inferiori a quelli ritenuti normali possono essere causati da aplasia midollare, da collagenopatie, da deficit di ferro, da deficit di vitamina B 12, da emorragie, da epatopatie, da infezioni gravi, da insufficienza renale cronica, da leucemie, da morbo di Cooley, da morbo di Crhon, da metrorragia, da neoplasie maligne, da ulcera peptica, da morbo di Hodgkin.
ERITROCITI (RBC) -MCH (Mean Corpuscolar Haemoglobin = quantità di emoglobina presente in ciascun globulo rosso) Hb/n° globuli rossi in milioni 2732 picogrammi -MCHC (Mean Corpuscolar Haemoglobin Concentration = concentrazione media di emoglobina in ciascun globulo) Hb/HMT 28 -36 g/100 ml di soli globuli rossi -MCT(Mean Corpuscolar Thickness = spessore medio di ciascun globulo rosso) 1, 7 -2, 5 micron - PCV (Packed Cell Volume = volume dei globuli ammassati rispetto al sangue totale) donna 36 -47% uomo 40 -50%
CONTENUTO EMOGLOBINICO CORPUSCOLARE MEDIO (MCH) E’ LA QUANTITA’ CONTENUTA IN MEDIA IN UN GLOBULO ROSSO VALORI NORMALI DA 27 A 32 pg
VOLUME CORPUSCOLATO MEDIO (MCV) INDICA LA GRANDEZZA DEI G. R. ED E’ IMPORTANTE PER LA DIAGNOSI DI ANEMIE V. G. R. < del normale anemia microcitica V. G. R. > del normale anemia macrocitica VALORI NORMALI DA 80 A 100 fl
CONCENTRAZIONE EMOGLOBINICA CORPUSCOLARE MEDIA (MCHC) INDICA SE I G. R. A SECONDA DELLA LORO GRANDEZZA CONTENGONO POCA O MOLTA EMOGLOBINA VALORI NORMALI DA 31 A 37 ( espressi in %) Valori < nelle anemie ipocromiche Valori > negli stati emolitici
RED – CELL DISTRIBUTION WIDTH (RDW) INDICA UNA MISURA DELL’AMPIEZZA DELLA CURVA DEI VOLUMI DEI G. R. PERMETTENDO COSI’ DI RICONOSCERE I CASI DI ANISOCITOSI VALORI NORMALI: DA 11. 5 A 14. 5 %
EMATOCRITO (HCT) E’ LA PERCENTUALE DI PARTE CORPUSCOLATA DEL SANGUE. VALORI NORMALI DONNA: DA 37 A 46 UOMO: DA 42 A 50
EMATOCRITO (HCT) • Esame che misura la quantità percentuale dei globuli rossi rispetto alla frazione liquida del sangue • Valori normali 40 - 54% per l’uomo, 35 - 47% per la donna. • Valori superiori da alcolismo diabete, insufficienza renale acuta, peritonite, policitemia, poliglobulia, uso di diuretici, ustioni, vomito, disidratazione • Valori inferiori da anemie, aplasie midollari, carenza di ferro, di vit B 12, cirrosi epatica, collagenopatie, emorragie, infezioni gravi, insufficienza renale cronica, leucemie, tumori maligni.
ERITROSEDIMENTAZIONE Tendenza dei globuli rossi del sangue a depositarsi sul fondo di un qualunque recipiente in cui venga posta una certa quantità di sangue reso incoagulabile. Tale processo in condizioni normali avviene molto lentamente, ma in molte condizioni morbose esso risulta accelerato, in molti casi proporzionalmente alla gravità della malattia. La sua valutazione, la misurazione cioè della velocità di e. o VES, costituisce un importante metodo di indagine diagnostica. Tale valutazione viene attuata riempiendo di sangue, reso incoagulabile con l’aggiunta di citrato di sodio, una apposita provetta graduata e leggendo successivamente dopo 1 ora e dopo 2 ore di quanto si sia abbassato il limite che separa il solo plasma, che resta in alto dalla colonna costituita dai globuli che si vanno portando verso il basso.
ERITROSEDIMENTAZIONE L’andamento globale del fenomeno viene espresso mediante un particolare indice (indice di Katz o K. ) ottenuto sommando il valore letto la prima ora alla metà del valore letto la seconda ora e dividendo quindi il risultato per due. La VES è condizionata dalle caratteristiche del plasma (in particolare dalla sua composizione proteica) e dei globuli rossi (forma, numero, tendenza ad aggregarsi ecc. ). Aumento della velocità di e. si osserva in molte malattie, anche di natura notevolmente diversa (infezioni, tumori, infiammazioni ecc. ). Vengono considerati normali valori compresi tra 4 e 10 per l'uomo, tra 4 e 15 per la donna.
PROFILO CITOLOGICO DEL SANGUE
Osservazione di uno striscio di sangue Un ingrandimento di 200 volte è sufficiente per osservare e identificare i differenti tipi di cellula. Tuttavia, un ingrandimento superiore vi permette di osservare meglio le cellule nei loro dettagli. Potete osservare subito lo striscio usando sia obiettivi a secco che ad immersione.
nello striscio di sangue la matrice extracellulare (plasma) viene eliminata e si osservano solo i cosiddetti elementi figurati, ovvero cellule o parti di cellule striscio gli elementi figurati del sangue vengono fissati e poi colorati con il metodo di Romanowski, cioè con una miscela di coloranti acidi, basici e neutri
Anemia da carenza di B 12
Anemia a cellule falciformi
LEUCOCITI (WBC) Chiamati anche globuli bianchi; sono conteggiati con speciali apparecchi contaglobuli. Ce ne sono di diversi tipi: basofili, eosinofili, linfociti, monociti, neutrofili. La loro funzione è quella di difendere l’organismo dalle infezioni. L’esame che evidenzia la percentuale dei diversi globuli bianchi presenti nel sangue si chiama formula leucocitaria. Sono considerati valori normali un numero di 4. 000 -10. 000 in un millilitro cubo di sangue. È molto importante, quando c’è un aumento di globuli bianchi, sapere quale tipo sia aumentato: in questo modo, si può stabilire che tipo di infezione è in atto. Valori elevati possono essere determinati da infiammazioni o infezioni: se aumentano i neutrofili la infezione è di natura batterica, se aumentano i linfociti è tendenzialmente di origine virale, se aumentano quelli eosinofili si può pensare o ad una allergia o ad una infestazione da parassiti. Quando i globuli bianchi raggiungono picchi altissimi (da 30 mila a centinaia di migliaia) si hanno le leucemie.
LEUCOCITI A differenza dei globuli rossi, i leucociti hanno il nucleo. Esso risulta ben visibile al microscopio dopo la colorazione dello striscio. Il nucleo di queste cellule può presentare lobature multiple, o essere indentato o reniforme. La forma del nucleo dei vari tipi di leucocita è generalmente diversa, insieme alla diversa colorazione dei granuli, ci aiuta al riconoscimento di queste cellule. I leucociti si dividono in granulociti e cellule linfoidi.
I LEUCOCITI (WBC) I leucociti, o globuli bianchi, sono incaricati della difesa dell'organismo. Nel sangue essi sono assai meno numerosi dei globuli rossi. La densità di leucociti nel sangue è di 4000 -10000 /mm 3. I leucociti si dividono in due categorie: granulociti e cellule linfoidi (o agranulociti). Il termine di granulociti è dovuto alla presenza di granuli nel citoplasma di queste cellule. Questi granuli sono differenti nei vari tipi di granulocita e ci aiutano a distinguerli. Infatti, questi granuli hanno una differente affinità verso i coloranti neutri, acidi o basici e fanno assumere al citoplasma un colore differente. I granulociti si distinguono dunque in neutrofili, eosinofili (o acidofili), basofili. Le cellule linfoidi, invece, si distinguono in linfociti e monociti. Ciascun tipo di leucocita è presente nel sangue in proporzioni diverse: granulocita neutrofilo 55 - 65 % granulocita eosinofilo 0 - 3% granulocita basofilo 0 - 2 % linfocita 20 - 35 % monocita 3 - 7 %
GRANULOCITI Derivano dal midollo osseo, il loro citoplasma è ricco di granuli che assumono colorazioni caratteristiche e che ne aiutano il riconoscimento. Il nucleo è raggruppato in masserelle o lobi. Nel sangue ci sono anche cellule immature. Esse si distinguono per avere il nucleo meno segmentato. Come abbiamo detto, ci sono tre tipi di granulociti: NEUTROFILI EOSINOFILI BASOFILI
NEUTROFILI (GRANULOCITI NEUTROFILI) Appartengono alla serie dei globuli bianchi e ne rappresentano la classe più numerosa; in genere aumentano nelle infezioni batteriche. Sono considerati normali valori un 40 -75% rispetto al totale dei leucociti (numero assoluto 1800 -7200). Valori superiori a quelli considerati normali possono essere determinati da artrite reumatoide, da emorragie, da gotta, da gravidanza, da infarto cardiaco, da infezioni acute ad esempio appendicite acuta, da leucemie, da neoplasie maligne, da pancreatite, da uso di farmaci cortisonici, da ustioni, da vaccinazioni. Valori inferiori a quelli considerati normali possono essere determinati da agranulocitosi, da anemie, da cirrosi epatica, da epatiti croniche, da influenza, da lupus eritematoso, da malaria, da mononucleosi, da morbillo, da parotite, da rosolia, da salmonellosi, da tifo, da intossicazione da benzolo, da piombo, da terapia radiante e antiblastica.
I neutrofili sono i leucociti più comuni. Hanno un diametro di 12 -15 µm. Si riconoscono per il nucleo suddiviso in 25 lobi, collegati da un sottile filamento di materiale nucleico. Il citoplasma è trasparente perchè ha granuli piccoli e debolmente colorati di rosa. I neutrofili immaturi hanno un nucleo nastriforme o a ferro di cavallo. Nel nucleo dei neutrofili delle femmine, è visibile un'appendice a forma di piccola mazza. E' il secondo cromosoma X, inattivato.
I neutrofili sono molto attivi nel fagocitare batteri e sono presenti in grandi quantità nel pus delle ferite. Purtroppo, queste cellule non sono capaci di rinnovare i lisosomi utilizzati nel digerire i microbi e muoiono dopo averne fagocitati alcuni.
I basofili sono i leucociti più rari (meno dell'1%). Sono relativamente piccoli: 9 -10 µm di diametro. Il citoplasma è molto ricco di granuli che prendono una colorazione porpora scuro. Nei basofili, la quantità di granuli è tale da nascondere il nucleo, generalmente bi-trilobato, che quindi è difficilmente visibile al microscopio.
BASOFILI Una delle forme dei globuli bianchi o leucociti. Valori normali 0 -2% del totale dei leucociti. Valori superiori a quelli normali possono essere determinati da epatite acuta, da insufficienza renale cronica, da leucemia, da morbillo, da pertosse, da rettocolite ulcerosa. Valori inferiori a quelli normali possono essere causati da gravidanza, da infezioni acute, da ipertiroidismo, da uso di estrogeni.
I basofili secernono sostanze anticoagulanti, vasodilatatrici come l'istamina e la serotonina. Anche se possiedono capacità fagocitaria, la loro funzione principale è quella di secernere sostanze che mediano la reazione di ipersensibilità.
EOSINOFILI E’ una varietà di globuli bianchi Valori normali fino a 250/mmc Valori superiori a quelli ritenuti normali possono essere causati da allergie, da eczemi, da granulomatosi, da leucemie, da morbo di Addison, da morbo di Hodgkin, da neoplasie maligne, da irradiazioni, da scarlattina Valori inferiori a quelli considerati normali possono essere causati da agranulocitosi, da insufficienza renale cronica, da interventi chirurgici, da ipotiroidismo, da shock anafilattico, da traumi, da uso di farmaci cortisonici
Gli eosinofili sono abbastanza rari nel sangue. La loro dimensione è la stessa dei neutrofili. Il nucleo è generalmente bilobato, ma sono stati osservati anche nuclei con 3 o 4 lobi. Il citoplasma è pieno di granuli che assumono un colore rosa-arancione caratteristico. Il nucleo risulta ancora ben visibile
Gli eosinofili aggrediscono parassiti e fagocitano i complessi antigene - anticorpo.
MONOCITI E' un tipo di leucociti. Sono cellule del sangue di grandi dimensioni, più grandi rispetto agli altri leucociti. Sono considerati valori normali un 2 -12% del numero totale dei leucociti (num. assoluto 200 -1000). Valori superiori a quelli considerati normali possono essere determinati da collagenopatie, da endocarditi, da leucemia, da morbo di Crohn, da malattia di Hodgkin, da mononucleosi, da neoplasie maligne, da rettocolite ulcerosa, da sarcoidosi, da tifo. Valori inferiori a quelli considerati normali possono essere determinati da anemie, da irradiazioni.
I monociti sono precursori dei macrofagi. Sono le cellule del sangue di dimensione maggiore. Quando nel midollo osseo raggiungono la maturità, vengono immessi nella circolazione sanguigna dove permangono per 24 -36 ore. Migrano poi nel tessuto connettivo, dove diventano macrofagi e si muovono nei tessuti. In presenza di un focolaio infiammatorio, i monociti migrano attivamente dai vasi sanguigni e iniziano una intensa attività fagocitaria. Il ruolo di queste cellule non si esaurisce nella fagocitosi poichè mostrano anche un'intensa attività di secrezione. Essi producono sostanze che hanno funzioni difensive, come il lisozima, gli interferoni ed altre sostanze che modulano la funzionalità di altre cellule. I macrofagi cooperano nella difesa immunitaria, espongono sulla membrana molecole dei corpi digeriti e li presentano alle cellule più specializzate, come i linfociti Th e B.
I monociti sono i leucociti più grossi: 16 -20 µm. Hanno un grosso nucleo reniforme o a ferro di cavallo, in certi casi anche bilobato. Il citoplasma è trasparente, ma con aspetto di "vetro smerigliato“.
LINFOCITI Cellule appartenenti a un gruppo di globuli bianchi di importanza essenziale per la funzionalità del sistema immunitario dell’organismo. Sono considerati valori normali un numero di 1500 -3000 in un millimetro cubo di sangue Valori superiori a quelli ritenuti normali possono essere determinati da artrite reumatoide, da epatite, da gotta, da infezioni, da morbo di Crohn, da mononucleosi, da pertosse, da uso di farmaci, da vaccinazioni. Valori inferiori a quelli ritenuti normali possono essere determinati da AIDS, da aplasia midollare, da insufficienza renale, da irradiazioni, da linfomi, da lupus eritematoso, da malattia di Hodgkin, da miastemia, da neoplasie maligne, da uso di farmaci citostatici e cortisonici.
La maggior parte dei linfociti circolanti nel sangue si trova allo stato di riposo. Essi hanno l'aspetto di piccole cellule con nucleo compatto che occupa quasi tutto il volume cellulare. Di conseguenza, il citoplasma è molto ridotto. I linfociti degli organi e dei tessuti linfoidi possono invece essere attivati in varia misura a seguito della stimolazione antigenica. Nel sangue, i linfociti rappresentano il 20 -40% di tutti i leucociti e possiedono una dimensione leggermente superiore a quella dei globuli rossi.
I linfociti sono abbastanza comuni nel sangue: 20 -40%. Con 8 -10 µm di diametro, sono in generale più piccoli degli altri leucociti, ma sono ancora un po' più grandi dei globuli rossi. Il citoplasma è trasparente. Il nucleo è rotondo e grande in rapporto alla cellula e la occupa quasi interamente. Resta comunque visibile un po' di citoplasma, in posizione generalmente laterale. A seconda della quantità di citoplasma presente, i linfociti si distinguono in piccoli, medi e grandi. Con la colorazione Giemsa, non ci sarà possibile distinguere i vari tipi di linfocita (B, T, NK) sia perchè nel sangue essi non sono attivati, sia perchè sarebbe necessario effettuare speciali colorazioni immunochimiche.
I linfociti sono cellule che, oltre a essere presenti nel sangue, popolano gli organi e i tessuti linfoidi, nonchè la linfa che circola nei vasi linfatici. Gli organi linfoidi comprendono il timo, il midollo osseo (negli uccelli la bursa), la milza, i linfonodi, le tonsille palatine, le placche di Peyer e il tessuto linfoide dei tratti respiratorio e digerente.
PIASTRINE (PLT) LA PRINCIPALE FUNZIONE DELLE PIASTRINE, O TROMBOCITI, È DI FERMARE LA PERDITA DI SANGUE NELLE FERITE (EMOSTASI). A TALE SCOPO, ESSE SI AGGREGANO E LIBERANO FATTORI CHE PROMUOVONO LA COAGULAZIONE DEL SANGUE. FRA QUESTE C'È LA SEROTONINA CHE RIDUCE IL CALIBRO DEI VASI LESIONATI E RALLENTA IL FLUSSO EMATICO, LA FIBRINA CHE INTRAPPOLA CELLULE E FORMA IL COAGULO. ANCHE SE APPAIONO DI FORMA TONDEGGIANTE, LE PIASTRINE NON SONO PROPRIAMENTE DELLE CELLULE. NEGLI STRISCI COLORATI CON IL GIEMSA, HANNO UN COLORE PORPORA INTENSO. IL LORO DIAMETRO È DI CIRCA 2 -3 µM, QUINDI SONO ASSAI PIÙ PICCOLE DEGLI ERITROCITI. VALORI NORMALI: DA 150. 000 A 350. 000 /mmc
PIASTRINE Sono i più piccoli elementi figurati del sangue che contribuiscono alla coagulazione; aggregandosi insieme in particolari situazioni (traumi, ferite, emorragie) bloccano le emorragie. La loro aggregazione è un fenomeno sfavorevole quando tende ad avvenire in condizioni normali, perchè può portare alla trombosi. La loro diminuzione causa alterazioni dell'emostasi con allungamento del tempo di emorragia. Vengono presi come valori di riferimento un numero di 150. 000 -400. 000 per millimetro cubo di sangue.
PIASTRINE • • • VN=150. 000 -350. 000 per millimetro cubo Valori superiori da carcinomi, carenza di ferro, da troppo esercizio fisico, da febbre reumatica, da infiammazioni, da leucemie, da morbo di Hodgkin, da osteomieliti, da parto, da policitemia, da splenectomia, da traumi, uso di vit B 12. Valori inferiori da anemia aplastica, deficit di vit. B 12, infezioni virali, leptospirosi, leucemia, linfomi, malaria, porpora, trasfusioni, antibiotici, barbiturici, diuretici, fenilbutazone, (FANS), ipoglicemizzanti, sulfamidici.
PIASTRINE Le piastrine non sono vere cellule. Sono prodotte per gemmazione dai megacariociti. Sono dischetti di piccole dimensioni (circa 3 µm). Appaiono di colore porpora più intenso dei globuli rossi.